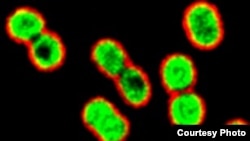
Multi-drug-resistant, gram-negative rod bacteria Acinetobacter baumannii being killed by azithromycin (green) in the presence of a human antimicrobial peptide naturally present at infection sites. (Credit: UC-San Diego School of Medicine)

A common antibiotic used for treating sore throats and ear infections may be a potent weapon against “superbugs” that are resistant to most other drugs.
In traditional laboratory tests against such bacteria, the antibiotic azithromycin, sold commercially as Zithromax, did not perform very well. But under different testing conditions, azithromycin proved highly effective against three difficult-to-treat pathogens.
Instead of doing the testing in a standard laboratory culture, scientists tested the drug in a culture that was more like the human body and contained a lot of human natural bacteria-fighting factors.
The resulting activity "was so potent that we could see that azithromycin was able to cure some of these infections in a mouse model of the drug-resistant pathogens,” said Victor Nizet, a professor of pediatrics and pharmacology at the University of California-San Diego.
Nizet’s group found that azithromycin, in this culture medium, zapped three “superbugs” — Pseudomonas aeruginosa, Klebsiella pneumoniae and Acinetobacter baumannii.
“Superbugs” are particularly lethal because they rarely strike healthy people. Instead, they tend to infect debilitated hospital patients with weakened immune systems, often killing them because no antibiotics are effective against the pathogens.
The highly resistant bacteria in this study are called gram-negative. This means they have cell walls and a structure that are difficult for antibiotic drugs to penetrate.
The World Health Organization warns drug resistance is spreading rapidly among these pathogens and is sounding the alarm that no new experimental antibiotics are on the horizon.
This study is important because it suggests some antibiotics that have been largely ignored in the treatment of serious infections could in fact save lives.
“If you are seeing a percentage of treatment failures with current antibiotic therapy, then it is important to step back and ask, 'Have we studied all of the antibiotics in the richest context that could yield the best treatment?' ” Nizet said.
While he said more research is needed, Nizet said it is possible physicians might want to try drugs like azithromycin, which have a proven safety record, in their sickest patients.
Results of the study by Nizet and colleagues are published in the journal EBioMedicine.